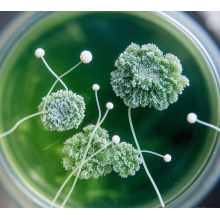
Let’s Talk About Mold

-
Oxygen is the first need of our life activities. Humans have been aware of the important role of oxygen for centuries, but how cells adapt to changing oxygen levels is unknown.
time2023/09/04
-
Hyperbaric chambers have significant effects on the treatment of cognitive dysfunction such as mild cognitive dysfunction, Alzheimer's disease, vascular cognitive dysfunction.
time2025/12/08
-
Hyperbaric oxygen therapy has been applied to the rehabilitation of excessive fatigue and motion sickness in sports athletes in various countries, as well as in daily training and major competitions.
time2023/02/03
-
On November 20, 2020, according to the Daily Mail, Israeli scientists have made breakthrough research. This is a biological study that can alter the state of aging.
time2025/11/11
-
Equipment Exhibition. At this exhibition, we launched multi-person oxygen chamber - spherical oxygen chamber.
time2023/02/03
-
oxy spaces break through the high-pressure technical barriers, the pressure value of the civil hyperbaric oxygen chamber to 2.0ATA, we continue to try, from product design, material selection.
time2023/02/03
-
OXYSPACES Space Oxygen Chamber Leads the Trend in Health Technology Innovation
time2024/06/28
-
-
-
Chronic Infections & Hyperbaric Therapy
time2026/01/06
-
Customer inspects OXYSPACES and experiences oxygen chambers
time2026/03/09
-
-
-
-
Fitness athletes using OXYSPACES oxygen chambersGenerate strong interest
time2024/07/31
-
-
-
-
-
-
-
Veterinary Health & Hyperbaric Therapy
time2024/09/18
-
-
OXYSPACES Oxygen Chamber Difference between medical hyperbaric oxygen chamber and hyperbaric oxygen chamber
time2024/10/08
-
-
Hyperbaric Oxygen Increases Stem Cell Proliferation, Angiogenesis and Wound-Healing Ability of WJ-MSCs in Diabetic Mice
time2024/10/22
-
Scleroderma is an autoimmune condition in which collagen deposits in abnormally high concentration in the subcutaneous tissue and other areas of the body. In some cases, this restricts blood supply to the skin and prevents normal wound healing. Wounds fester and become infected, decreasing oxygen delivery even further. Hyperbaric oxygen delivers oxygen to ischemic, marginal wounds and is known to accelerate wound healing by as much as 50%.
time2024/10/29
-
Hyperbaric oxygen ameliorates worsening signs and symptoms of post-traumatic stress disorder
time2024/11/05
-
Hyperbaric Oxygen Therapy (HBOT) is a method that utilizes a high-pressure environment and pure oxygen or high concentrations of oxygen to treat various hypoxic diseases and related conditions. Its development history can be traced back to early diving and underwater operations, which laid the foundation for subsequent hyperbaric oxygen medicine.
time2024/11/11
-
OXYSPACES Hyperbaric Chambers Showcase Innovation in Hyperbaric Oxygen Therapy at MEDICA2024
time2024/11/19
-
Low pressure hyperbaric oxygen therapy and SPECT brain imaging in the treatment of blast-induced chronic traumatic brain injury (post-concussion syndrome) and post traumatic stress disorder: a case report
time2024/11/26
-
Hyperbaric oxygen therapy and cancer—a review
time2024/12/03
-
Hyperbarics For Breast Cancer Radiation Tissue Toxicity
time2024/12/10
-
There is painfully little research done on the effects of using hyperbaric therapy to combat drug addiction, but we feel it has the potential to be one of the most effective ways to help a person come down from any type of drug addiction. One research study conducted in 2016 found that one hour of hyperbaric therapy greatly reduced the withdrawal symptoms in mice who were given morphine for several days.
time2024/12/17
-
Pediatric Autoimmune Neuropsychiatric Disorder Associated with Streptococcal Infections (PANDAS) and Pediatric Acute-Onset Neuropsychiatric Syndrome (PANS) are two conditions that were once obscure but are now gaining widespread recognition. Both are autoimmune disorders stemming from chronic infections. The initial association with strep infections led to the specific diagnosis of PANDAS.
time2024/12/24
-
Hyperbaric oxygen treatment in autism spectrum disorders
time2024/12/31
-
Mold illness is quite common but often misdiagnosed. When a patient presents with mold toxicity symptoms, it can often look like a wide variety of other chronic conditions. Because most doctors have very little experience with mold illness, they rarely consider it when ruling out conditions for their sick patients. If left untreated, mold illness can become chronic, even when the patient escapes the moldy environment. Severe mold toxicity can also be deadly.
time2025/01/07
-
-
-